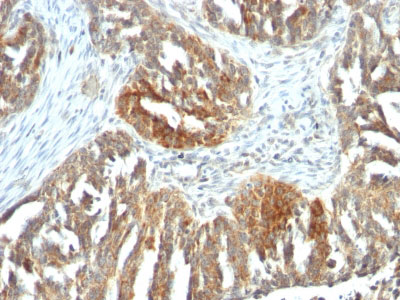

> Antigen, Antibodies, ELISA, Western Blot > Primary Antibody > Monoclonal Antibodies > VEGF (Vascular Endothelial Growth Factor) Antibody - Without BSA and AzideBrand |
Leading Biology | Catalog Number |
APG01369G |
Product Type |
Monoclonal Antibodies | Field of Research |
|
Product Overview |
We constantly strive to ensure we provide our customers with the best antibodies. As a result of this work we offer this antibody in purified format.
We are in the process of updating our datasheets. If you have any questions regarding this update, please feel free to contact our technical support team.
This product is a high quality VEGF (Vascular Endothelial Growth Factor) antibody - Without BSA and Azide.
|
||
Molecular Weight |
19-22kDa (reducing) and 38kDa-44kDa (non-reducing)
|
||
Cellular Localization |
Antigen Cellular Localization:
Secreted Note=VEGF121 is acidic and freely secreted. VEGF165 is more basic, has heparin-binding properties and, although a signicant proportion remains cell-associated, most is freely secreted VEGF189 is very basic, it is cell-associated after secretion and is bound avidly by heparin and the extracellular matrix, although it may be released as a soluble form by heparin, heparinase or plasmin
|
||
Host |
Mouse
|
||
Species Reactivity |
Human, Mouse, Rat, Rabbit, Dog
|
||
Clone |
VEGF/1063
|
||
Isotype |
Mouse / IgG1, kappa
|
||
Symbol |
VEGF
|
||
GeneID |
|||
UniProt ID |
|||
Function |
Growth factor active in angiogenesis, vasculogenesis and endothelial cell growth. Induces endothelial cell proliferation, promotes cell migration, inhibits apoptosis and induces permeabilization of blood vessels. Binds to the FLT1/VEGFR1 and KDR/VEGFR2 receptors, heparan sulfate and heparin. NRP1/Neuropilin-1 binds isoforms VEGF-165 and VEGF-145. Isoform VEGF165B binds to KDR but does not activate downstream signaling pathways, does not activate angiogenesis and inhibits tumor growth.
|
||
Summary |
This MAb recognizes proteins of 19-22kDa (reducing) and 38kDa-44kDa (non-reducing), identified as various isoforms of Vascular Endothelial Growth Factor or Vascular Permeability Factor (VEGF/VPF). It is highly specific to VEGF, which is a homodimeric, disulfide-linked glycoprotein with a close homology to platelet derived growth factor (PDGF). There are multiple isoforms of VEGF containing 206-, 189-, 165-, and 121-amino acid residues. The smaller two isoforms, VEGF165 and VEGF121, are secreted proteins and act as diffusible agents, whereas the larger two remain cell associated. VEGF/VPF plays an important role in angiogenesis, which promotes tumor progression and metastasis.
|
||
Form |
Liquid |
||
Storage & Stability |
Store at +4°C short term. For long-term storage, aliquot and store at -20°C or below. Stable for 12 months at -20°C. Avoid repeated freeze-thaw cycles.
|
||
Applications |
IHC, IF
|
||
Synonyms |
Vascular endothelial growth factor A, VEGF-A, Vascular permeability factor, VPF, VEGFA, VEGF
|
||
Images |
Formalin-fixed, paraffin-embedded human Ovarian Carcinoma stained with VEGF Monoclonal Antibody (VEGF/1063). 
Formalin-fixed, paraffin-embedded human Tonsil stained with VEGF Monoclonal Antibody (VEGF/1063). |
||
Specification |
|||
Quantity |
|
||
| Select | Brand | Catalog No. | Product Name | Pack Size | Type | Field of Research | Specification | Quantity | Price(USD) | |
| 1 | Leading Biology | APG02467G | CCK4 / PTK7 Antibody (clone 4F9) | 50 μl | Monoclonal Antibodies |
|
$495.00 | Add Ask | ||
| 2 | Leading Biology | AMM04683G | GALT Antibody (clone 4C11) | 50 μg | Monoclonal Antibodies |
|
$545.00 | Add Ask | ||
| 3 | Leading Biology | AMM01402G | Vimentin (Mesenchymal Cell Marker) Antibody - With BSA and Azide | 50 ug | Monoclonal Antibodies |
|
$395.00 | Add Ask | ||
| 4 | Leading Biology | APR08280G | LTA4H / LTA4 Antibody (clone 9G8) | 50 μl | Monoclonal Antibodies |
|
$495.00 | Add Ask | ||
| 5 | Leading Biology | AMM00172G | CD1a / HTA1 (Mature Langerhans Cells Marker) Antibody - With BSA and Azide | 50 ug | Monoclonal Antibodies |
|
$395.00 | Add Ask | ||
| 6 | Leading Biology | AMM05750G | CEBPA Antibody | 100 μl | Monoclonal Antibodies |
|
$545.00 | Add Ask |
 Leading Biology Inc.
2600 Hilltop DR, Building G, B Suite C138
Richmond, CA, 94806
Tel: 1-661-524(LBI)-0262
Email: info@leadingbiology.com
Leading Biology Inc.
2600 Hilltop DR, Building G, B Suite C138
Richmond, CA, 94806
Tel: 1-661-524(LBI)-0262
Email: info@leadingbiology.com
Complete this form and click send to ask us a question, request a quote or simply say hello.

You have 0 item in your cart

You have 0 item in your inquiry list
